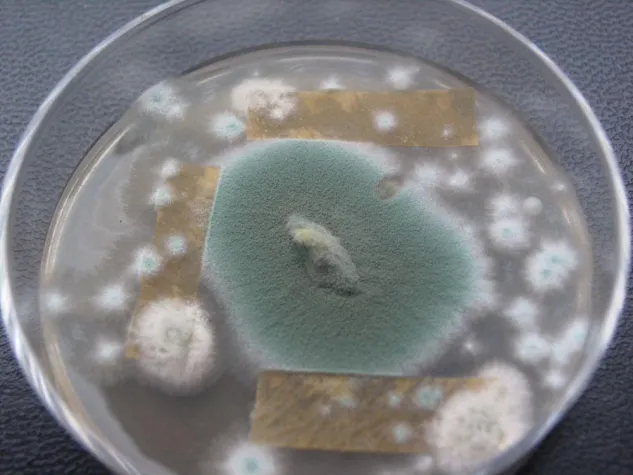
Bild: Schimmelpilze in Innenräumen - ein zunehmendes Problem

(openPR) Bericht von der interdisziplinären Tagung zu gesundheitlichen Auswirkungen von Schimmelpilzbefall
Mit rund 140 Teilnehmern war die 3. Hamburger Fachtagung „Schimmelpilze in Innenräumen“ organisiert vom Regionalverband Umweltberatung Nord e.V.“ gut besucht. Darunter befanden sich Vertreter des Bundesverbands für Umweltberatung e.V., des Umweltbundesamtes sowie zahlreicher Verbände und Behörden, die als Kooperationspartner beteiligt waren. Bei der Veranstaltung, die am 30. September 2008 in der Universität Hamburg stattfand, standen die gesundheitlichen Auswirkungen im Mittelpunkt. „Deshalb freuen wir uns besonders, dass auch zahlreiche Ärzte an der Tagung teilgenommen haben“, sagt Organisatorin Meike Ried. Die Veranstaltung stand unter der Schirmherrschaft von Senatorin Anja Hajduk, die in ihrem Grußwort die Aktivitäten des Regionalverbands Umweltberatung Nord zur Vernetzung unterschiedlichster Fachleute im Problemfeld Schimmel lobte.
Übereinstimmend waren die Mahnungen der sieben Referenten, dem Wohnungsschimmel mehr Aufmerksamkeit zu widmen, da sie eine weitere Zunahme befürchten. Steigende Energiepreise verführen gerade Haushalte mit geringem Einkommen dazu, beim Heizen und Lüften zu sparen. Damit steigt jedoch auch die Luftfeuchtigkeit in Innenräumen und die Schimmelgefahr. „Um Schimmels Willen“ meinte Dr. Heike Otremba vom Gesundheitsamt Bremen. Sie stellte die gleichnamige Bremer Studie vor, in der festgestellt wurde, dass Menschen mit wenig Geld die Verlierer in Sachen Wohnungsschimmel sind. Eine Qualitätssicherung für Schimmelpilzuntersuchungen hält Dr. Birger Heinzow vom Landesamt für soziale Dienste in Kiel für dringend erforderlich, da die Gefahr besteht, dass mit Schimmelpilzen Panikmache betrieben wird und Laboruntersuchungen als gewinnträchtige Einkommensquelle missbraucht werden. Wie Dr. Regine Szewzyk vom Umweltbundesamt zeigte, sind Feuchteschäden in der Wohnung ein Risikofaktor für die Entwicklung einer Schimmelpilzallergie bei Kindern. Dabei können prinzipiell alle Schimmelpilzarten eine Allergie auslösen. Szewzyk stellte Ergebnisse des Kinder-Umwelt-Surveys des Umweltbundesamtes vor, einer repräsentativen Studie, in der 1.800 Kinder auf allergische Erkrankungen durch Innenraumschadstoffe untersucht wurden. Die mietrechtliche Lage bei Auftreten von Wohnungsschimmel erläuterte Rechtsanwalt Alexander Blazek von Haus und Grund Schleswig-Holstein umfassend und verständlich. Wie reagieren Menschen, die in einem schimmelpilzbelasteten Umfeld leben und wie lässt sich eine gesundheitliche Reaktion auf Schimmelpilze diagnostizieren, war das Thema, über das Umweltmediziner Dr. Thomas Fenner referierte. Sozusagen als Pendant ging es in dem Vortrag von Dr. Ulrike Swida vom Amt für Arbeitsschutz um Schutzmaßnahmen bei Tätigkeiten in schimmelpilzbefallenen Räumen. Abgerundet wurde das Themenspektrum mit einem Vortrag von Diplomingenieur Wilhelm Reiners über Lüftungskonzepte zur Vorbeugung von Schimmelpilzen.
Die Vorträge sind in Kurzform in einem Tagungsband zusammengefasst, der zum Preis von 12,80 Euro bestellt werden kann unter
Veranstalter : Regionalverband Umweltberatung Nord e.V., Herzmoortwiete 2, 22417 Hamburg, Tel.:040/40 40 05, Fax: 040/530 50 781, E-Mail:
Kooperationspartner : Ärztekammer Hamburg, Berufsverband Deutscher Baubiologen, Bundesverband der Brand- und Wasserschadenbeseitiger, Bundesverband für Wohnungslüftung, Bundesverband Schimmelpilzsanierung (BSS), Deutscher Mieterbund - Landesverband Hamburg, Deutsches Energieberater Netzwerk (DEN), Grundeigentümer-Verband Hamburg, Initiative Arbeit & Klimaschutz, Mieter helfen Mietern e.V., Umweltberatungen der Bezirksämter, Umweltbundesamt, Verband für Haus- und Wohneigentum, Verband norddeutscher Wohnungsunternehmen, Verbraucherzentrale Hamburg, VDI-Arbeitskreise Bautechnik, Umweltschutztechnik, Technische Gebäudeausrüstung, Zentrum für Energie, Bauen, Architektur und Umwelt (ZEBAU), Zentrum für zukunftsorientiertes Bauen (ZzB).